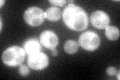
YKR048C

View description
Protein that interacts with mitotic cyclin Clb2p; required for the regulation of microtubule dynamics during mitosis; controls bud morphogenesis; involved in the transport of H2A and H2B histones to the nucleus; phosphorylated by CK2
Localization:
Intensity:
Fold change:
Significance:
-
C’ GFP library in SD
cytosol100.99 -
N' NOP1pr-GFP in SD

cytosol176.294 -
N' TEF2pr-mCherry in SD

cytosol208.626 -
N' NATIVEpr-GFP in SD

bud neck45.8899 -
N' TEF2pr-VC and Cyto-VN in SD

#N/A0 -
C’ GFP library in SD+DTT

cytosol100.991No -
C’ GFP library in SD+H2O2

cytosol107.741.06No -
C’ GFP library in Starvation Media

cytosolN/AN/AYes -
C’ GFP library on the background of Pup2-DaMP

N/A -
C’ GFP library on the background of CCT mutant

N/A0N/AYes
